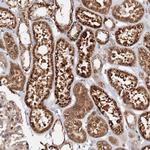
DCTD Antibody in Immunohistochemistry (Paraffin) (IHC (P))

Search
Invitrogen
DCTD Polyclonal Antibody
{{$productOrderCtrl.translations['antibody.pdp.commerceCard.promotion.promotions']}}
{{$productOrderCtrl.translations['antibody.pdp.commerceCard.promotion.viewpromo']}}
{{$productOrderCtrl.translations['antibody.pdp.commerceCard.promotion.promocode']}}: {{promo.promoCode}} {{promo.promoTitle}} {{promo.promoDescription}}. {{$productOrderCtrl.translations['antibody.pdp.commerceCard.promotion.learnmore']}}
产品信息
PA5-57451
种属反应
宿主/亚型
分类
类型
抗原
偶联物
形式
浓度
规格
纯化类型
保存液
内含物
保存条件
运输条件
RRID
产品详细信息
Immunogen sequence: QPCGPNMSEV SCKKRDDYLE WPEYFMAVAF LSAQRSKDPN SQVGACIVNS ENKIVGIGYN GMPNGCSDDV LPWRRTAENK LDTKYPYVCH A
Highest antigen sequence identity to the following orthologs: Mouse - 90%, Rat - 90%.
靶标信息
The protein encoded by this gene catalyzes the deamination of dCMP to dUMP, the nucleotide substrate for thymidylate synthase. The encoded protein is allosterically activated by dCTP and inhibited by dTTP, and is found as a homohexamer. This protein uses zinc as a cofactor for its activity. Two transcript variants encoding different isoforms have been found for this gene.
仅用于科研。不用于诊断过程。未经明确授权不得转售。
篇参考文献 (0)
生物信息学
蛋白别名: dCMP deaminase; Deoxycytidylate deaminase; unnamed protein product
基因别名: DCTD
UniProt ID: (Human) P32321
Entrez Gene ID: (Human) 1635